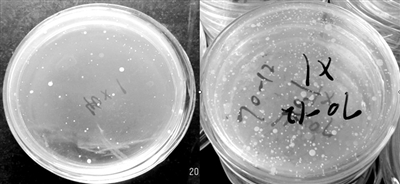

![]() |
????實驗室對54條干用毛巾和65條濕用毛巾做了菌落數測試,上述環(huán)境下40天和20天后,細菌超標。
????“毛巾健康使用研究課題組”供圖
????每天都要與之“親密接觸”的毛巾,很多人往往一用就是半年甚至更久才會更換,也不知定期消毒,這些其實都是不良習慣,對健康不利。
????在昨日召開的中國家紡大會上,中國家用紡織品行業(yè)協(xié)會毛巾專業(yè)委員會發(fā)布毛巾健康使用周期實驗檢測結果,顯示毛巾使用越久,越易滋生細菌,即使在定期消毒情況下,也最好每3個月更換一次;而微波高溫消毒,則是最有效的滅菌方法。
????據介紹,此次毛巾健康使用研究課題組選定413名志愿者進行了模擬毛巾使用實驗,設定不同的使用環(huán)境、洗滌次數、洗滌方式、晾干方式等條件。同時從北京、南京、深圳、西安、濱州5個不同地域的家庭取得167份純棉毛巾進行了細菌數量測試。
????全國家紡標委會毛巾分技術委員會秘書長、高級工程師杜換福指出,不科學的使用習慣,如一巾多用、多人一巾、不破不換等,導致在使用過程中,隨著時間的推移毛巾會發(fā)硬和滋生細菌,容易導致皮膚過敏、炎癥,對過敏性皮膚尤其更為明顯。同時,用久了的毛巾又臟又硬,會成為新的污染源。
????■ 調查
????八成受訪者毛巾超半年一換
????實驗樣品
????從北京、南京、深圳、西安、濱州5個不同地域的家庭取得的167份毛巾
????實驗地點
????亞光家紡公司國家認可實驗室
????實驗時間
????2012年3月到2013年10月
????昨日,記者隨機詢問15位消費者,只有3位表示使用3個月內會換毛巾,其中1位每月?lián)Q一次。而有7名消費者都是在毛巾使用半年以上再更換,還有3位對毛巾的使用時間超過1年,2位告知“如果毛巾不壞就一直用”。
????而課題組此前通過發(fā)放300份問卷調查顯示,逾80%消費者都是半年以上才換毛巾。
????此外,毛巾廠家在標識使用說明上,也并沒有提示并引導消費者正確使用。
????昨天下午,記者走訪豐臺區(qū)部分超市、市場,在毛巾貨架上,查詢多個品牌的多款洗臉巾、浴巾,發(fā)現(xiàn)縫在上面的標簽上,印制的使用說明中有的提示“使用初期有脫色的可能”、“刺繡部分勿直接接觸皮膚”等字樣,但都未提及毛巾使用時間的問題,消費者不得而知。
????一位毛巾攤位銷售者告訴記者,一般是建議使用3個月就更換,但這只是一個建議,不做統(tǒng)一要求,個人使用情況不同,因而也沒有要求一定要印在使用說明上。
????杜換福昨晚透露,40家毛巾廠家已注意到這種情況,集體向協(xié)會提議,正在考慮統(tǒng)一在毛巾上掛出標簽,提示消費者如何健康使用毛巾。
????實驗 1
????毛巾干用比濕用滋生細菌慢
????實驗過程:模擬在干燥和濕潤環(huán)境下,對志愿者的54條干用毛巾和65條濕用毛巾做菌落數測試,測試毛巾在什么環(huán)境下容易滋生細菌。
????實驗結果:杜換福介紹,按照《旅店業(yè)衛(wèi)生標準》GB9663-1996公共用品清洗消毒判定標準規(guī)定,毛巾的細菌總數應不超過200cfu/25cm2。但實驗發(fā)現(xiàn),北方室內環(huán)境(干燥)和南方室內環(huán)境(濕潤)下,毛巾分別使用40天和20天,細菌就超標了,其中在濕潤條件下比干燥條件下,毛巾更快更容易滋生細菌。
????【提醒】 在晾干條件下,洗滌次數對細菌滋生有比較大的影響,每次洗滌晾干后的細菌滋生較慢,因此建議在定期消毒的情況下,也最好每3個月更換一次毛巾。
????實驗 2
????微波爐高火5分鐘內即滅菌
????實驗過程:課題組實驗人員把從消費者處選取的毛巾清洗后,分別采用微波爐、沸水煮、高壓鍋汽蒸這3種方式,對毛巾進行高溫消毒,看哪種消毒方式最有效。
????實驗結果:把毛巾放到微波爐專用保鮮盒內,調到高火3到5分鐘,測試發(fā)現(xiàn)毛巾的菌落數殺滅率達98%。而把毛巾放到沸水煮5分鐘,只能殺死一般細菌的繁殖體。毛巾放到高壓鍋內汽蒸,溫毒達120-150℃,需要蒸10-15分鐘,才能100%滅菌。
????【提醒】 杜換福介紹,用沸水煮和高壓鍋汽蒸,會影響毛巾的色牢度和強度,不建議經常使用。而微波消毒效果可靠,殺菌快,且無化學消毒劑不良反應,是比較理性的消毒方法,建議應每7到10天就對毛巾高溫消毒一次。
????另外,肥皂、香皂都屬于堿性,清洗毛巾后容易變硬,最好使用中性的洗滌劑。
相關新聞
|